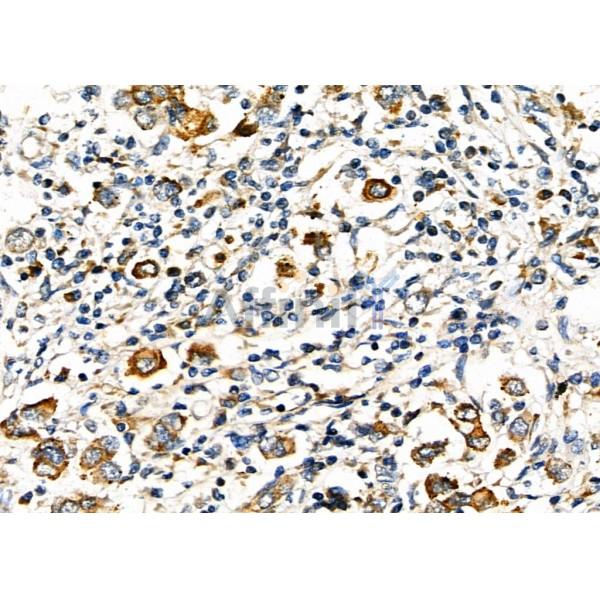
HAVCR2 Antibody - DF6979 at 1/100 staining Human mammary cancer by IHC-P.

HAVCR2 Antibody - #DF6979
| Product: | HAVCR2 Antibody |
| Catalog: | DF6979 |
| Description: | Rabbit polyclonal antibody to HAVCR2 |
| Application: | WB IHC |
| Cited expt.: | WB |
| Reactivity: | Human, Rat |
| Prediction: | Horse, Dog |
| Mol.Wt.: | 33kDa; 33kD(Calculated). |
| Uniprot: | Q8TDQ0 |
| RRID: | AB_2838935 |
Related Downloads
Protocols
Product Info
*The optimal dilutions should be determined by the end user. For optimal experimental results, antibody reuse is not recommended.
*Tips:
WB: For western blot detection of denatured protein samples. IHC: For immunohistochemical detection of paraffin sections (IHC-p) or frozen sections (IHC-f) of tissue samples. IF/ICC: For immunofluorescence detection of cell samples. ELISA(peptide): For ELISA detection of antigenic peptide.
Cite Format: Affinity Biosciences Cat# DF6979, RRID:AB_2838935.
Fold/Unfold
CD366; FLJ14428; HAVcr-2; Havcr2; HAVR2_HUMAN; Hepatitis A virus cellular receptor 2; Kidney injury molecule 3; KIM 3; KIM3; T cell immunoglobulin and mucin domain containing 3; T cell immunoglobulin mucin 3; T-cell immunoglobulin and mucin domain-containing protein 3; T-cell immunoglobulin mucin family member 3; T-cell immunoglobulin mucin receptor 3; T-cell membrane protein 3; Tim 3; TIM-3; TIM3; TIMD-3; TIMD3;
Immunogens
A synthesized peptide derived from human HAVCR2, corresponding to a region within C-terminal amino acids.
Expressed in T-helper type 1 (Th1) lymphocytes. Expressed on regulatory T (Treg) cells after TCR stimulation. Expressed in dendritic cells and natural killer (NK) cells. Expressed in epithelial tissues. Expression is increased on CD4+ and CD8+ T-cells in chronic hepatitis C virus (HCV) infection. In progressive HIV-1 infection, expression is up-regulated on HIV-1-specific CD8 T-cells.
- Q8TDQ0 HAVR2_HUMAN:
- Protein BLAST With
- NCBI/
- ExPASy/
- Uniprot
MFSHLPFDCVLLLLLLLLTRSSEVEYRAEVGQNAYLPCFYTPAAPGNLVPVCWGKGACPVFECGNVVLRTDERDVNYWTSRYWLNGDFRKGDVSLTIENVTLADSGIYCCRIQIPGIMNDEKFNLKLVIKPAKVTPAPTRQRDFTAAFPRMLTTRGHGPAETQTLGSLPDINLTQISTLANELRDSRLANDLRDSGATIRIGIYIGAGICAGLALALIFGALIFKWYSHSKEKIQNLSLISLANLPPSGLANAVAEGIRSEENIYTIEENVYEVEEPNEYYCYVSSRQQPSQPLGCRFAMP
Predictions
Score>80(red) has high confidence and is suggested to be used for WB detection. *The prediction model is mainly based on the alignment of immunogen sequences, the results are for reference only, not as the basis of quality assurance.
High(score>80) Medium(80>score>50) Low(score<50) No confidence
Research Backgrounds
Cell surface receptor implicated in modulating innate and adaptive immune responses. Generally accepted to have an inhibiting function. Reports on stimulating functions suggest that the activity may be influenced by the cellular context and/or the respective ligand. Regulates macrophage activation. Inhibits T-helper type 1 lymphocyte (Th1)-mediated auto- and alloimmune responses and promotes immunological tolerance. In CD8+ cells attenuates TCR-induced signaling, specifically by blocking NF-kappaB and NFAT promoter activities resulting in the loss of IL-2 secretion. The function may implicate its association with LCK proposed to impair phosphorylation of TCR subunits, and/or LGALS9-dependent recruitment of PTPRC to the immunological synapse. In contrast, shown to activate TCR-induced signaling in T-cells probably implicating ZAP70, LCP2, LCK and FYN (By similarity). Expressed on Treg cells can inhibit Th17 cell responses. Receptor for LGALS9. Binding to LGALS9 is believed to result in suppression of T-cell responses; the resulting apoptosis of antigen-specific cells may implicate HAVCR2 phosphorylation and disruption of its association with BAG6. Binding to LGALS9 is proposed to be involved in innate immune response to intracellular pathogens. Expressed on Th1 cells interacts with LGALS9 expressed on Mycobacterium tuberculosis-infected macrophages to stimulate antibactericidal activity including IL-1 beta secretion and to restrict intracellular bacterial growth (By similarity). However, the function as receptor for LGALS9 has been challenged. Also reported to enhance CD8+ T-cell responses to an acute infection such as by Listeria monocytogenes (By similarity). Receptor for phosphatidylserine (PtSer); PtSer-binding is calcium-dependent. May recognize PtSer on apoptotic cells leading to their phagocytosis. Mediates the engulfment of apoptotic cells by dendritic cells. Expressed on T-cells, promotes conjugation but not engulfment of apoptotic cells. Expressed on dendritic cells (DCs) positively regulates innate immune response and in synergy with Toll-like receptors promotes secretion of TNF-alpha. In tumor-imfiltrating DCs suppresses nucleic acid-mediated innate immune repsonse by interaction with HMGB1 and interfering with nucleic acid-sensing and trafficking of nucleid acids to endosomes (By similarity). Expressed on natural killer (NK) cells acts as a coreceptor to enhance IFN-gamma production in response to LGALS9. In contrast, shown to suppress NK cell-mediated cytotoxicity. Negatively regulates NK cell function in LPS-induced endotoxic shock (By similarity).
O-glycosylated with core 1 or possibly core 8 glycans.
Phosphorylated on tyrosine residues; modestly increased after TCR/CD28 stimulation. Can be phosphorylated in the cytoplasmatic domain by FYN (By similarity). Phosphorylation at Tyr-265 is increased by stimulation with ligand LGALS9.
Membrane>Single-pass type I membrane protein. Cell junction. Cell membrane.
Note: Localizes to the immunological synapse between CD8+ T-cells and target cells.
Expressed in T-helper type 1 (Th1) lymphocytes. Expressed on regulatory T (Treg) cells after TCR stimulation. Expressed in dendritic cells and natural killer (NK) cells. Expressed in epithelial tissues. Expression is increased on CD4+ and CD8+ T-cells in chronic hepatitis C virus (HCV) infection. In progressive HIV-1 infection, expression is up-regulated on HIV-1-specific CD8 T-cells.
Belongs to the immunoglobulin superfamily. TIM family.
References
Application: WB Species: Mouse Sample: GC cells
Restrictive clause
Affinity Biosciences tests all products strictly. Citations are provided as a resource for additional applications that have not been validated by Affinity Biosciences. Please choose the appropriate format for each application and consult Materials and Methods sections for additional details about the use of any product in these publications.
For Research Use Only.
Not for use in diagnostic or therapeutic procedures. Not for resale. Not for distribution without written consent. Affinity Biosciences will not be held responsible for patent infringement or other violations that may occur with the use of our products. Affinity Biosciences, Affinity Biosciences Logo and all other trademarks are the property of Affinity Biosciences LTD.